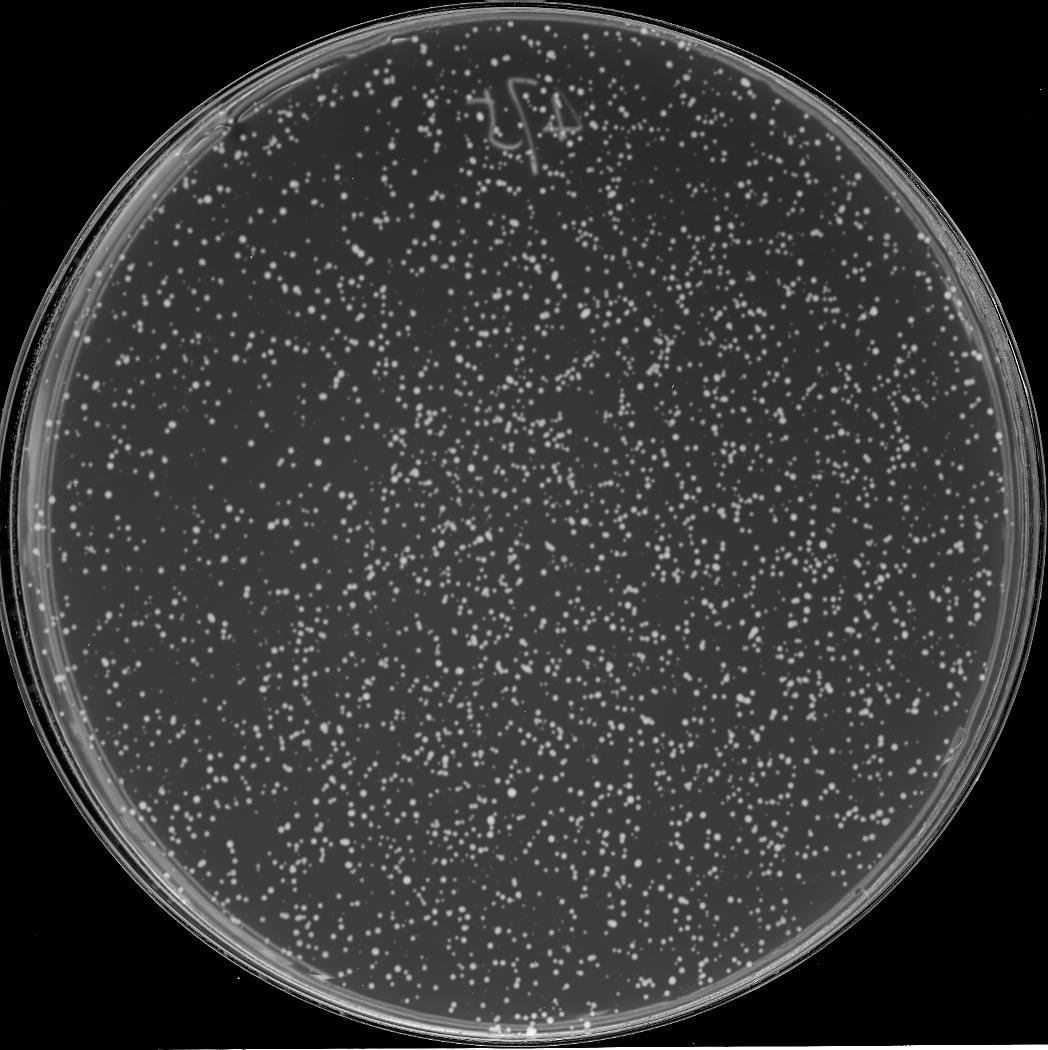
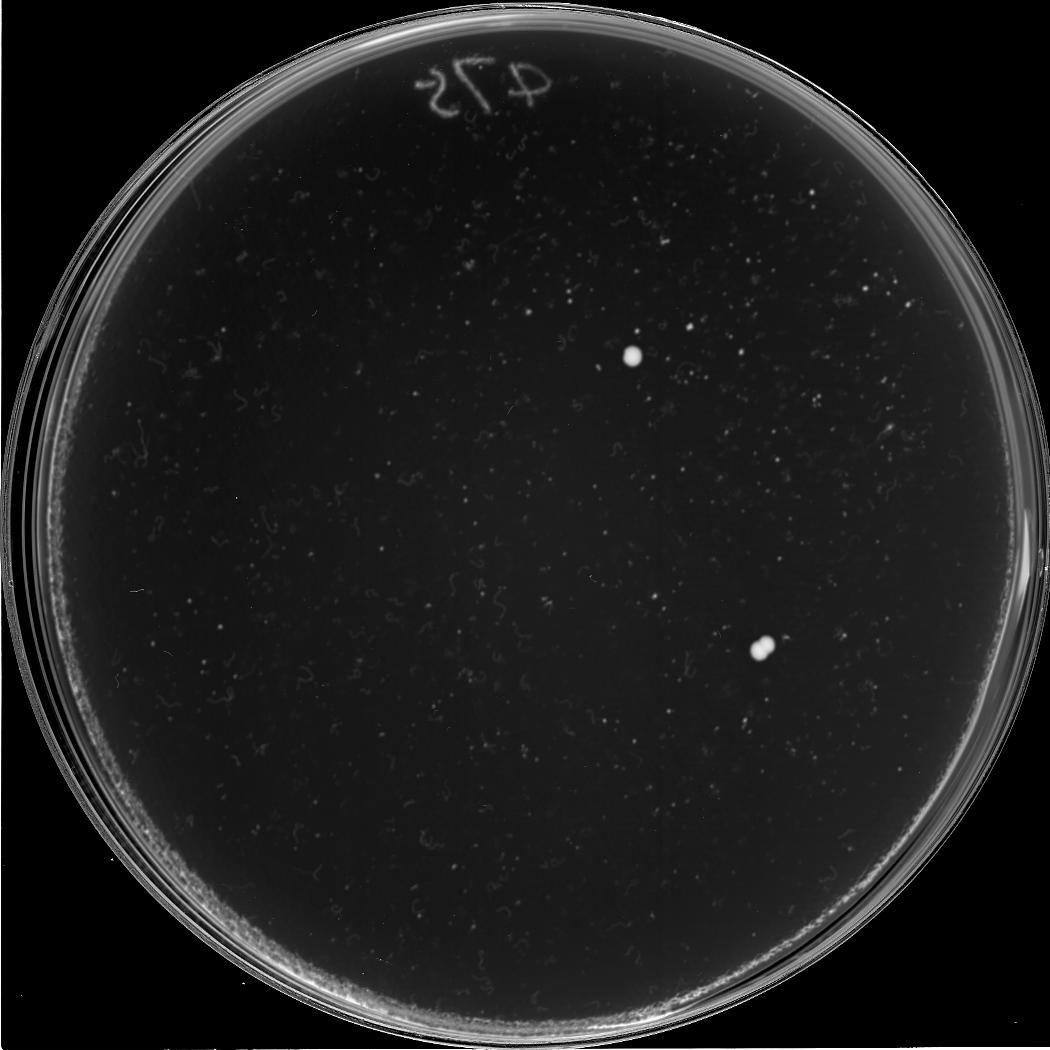
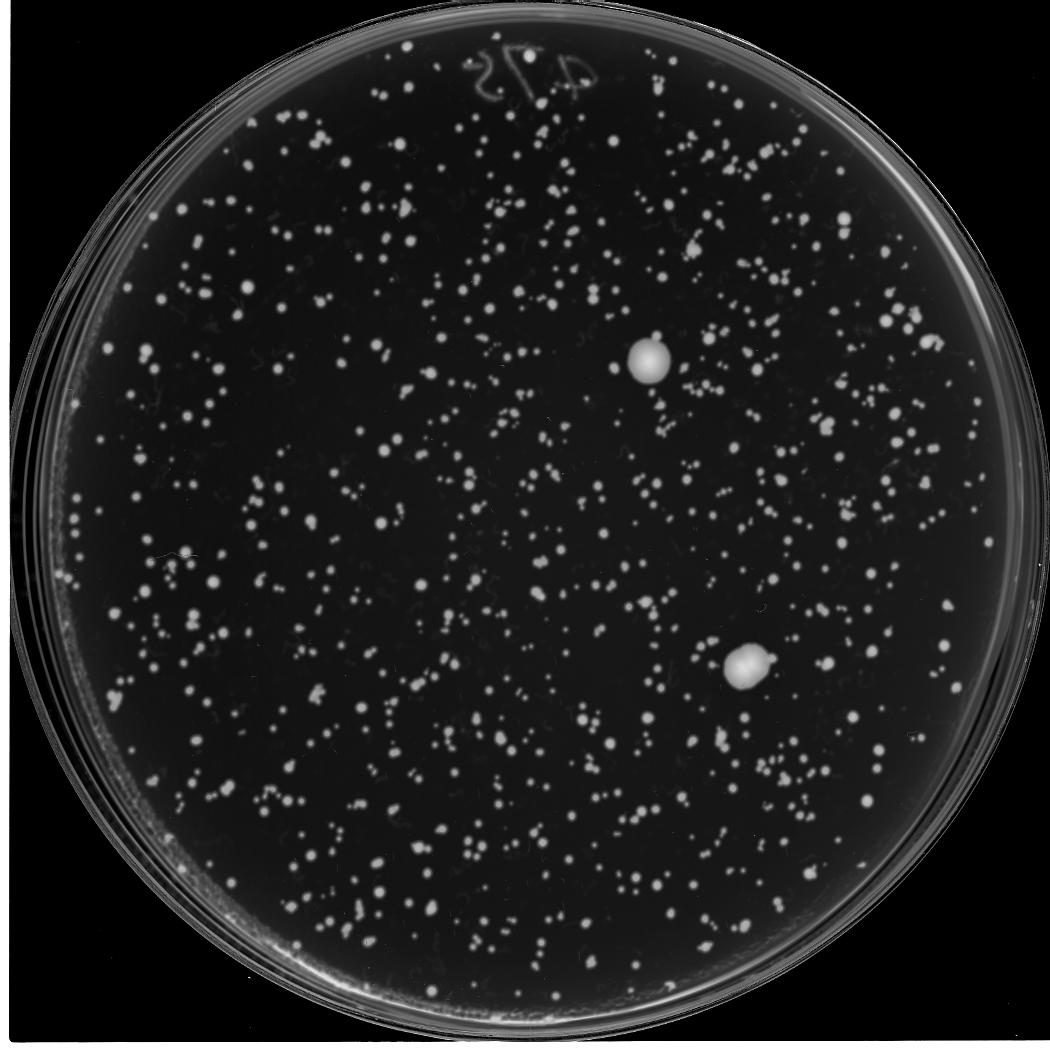
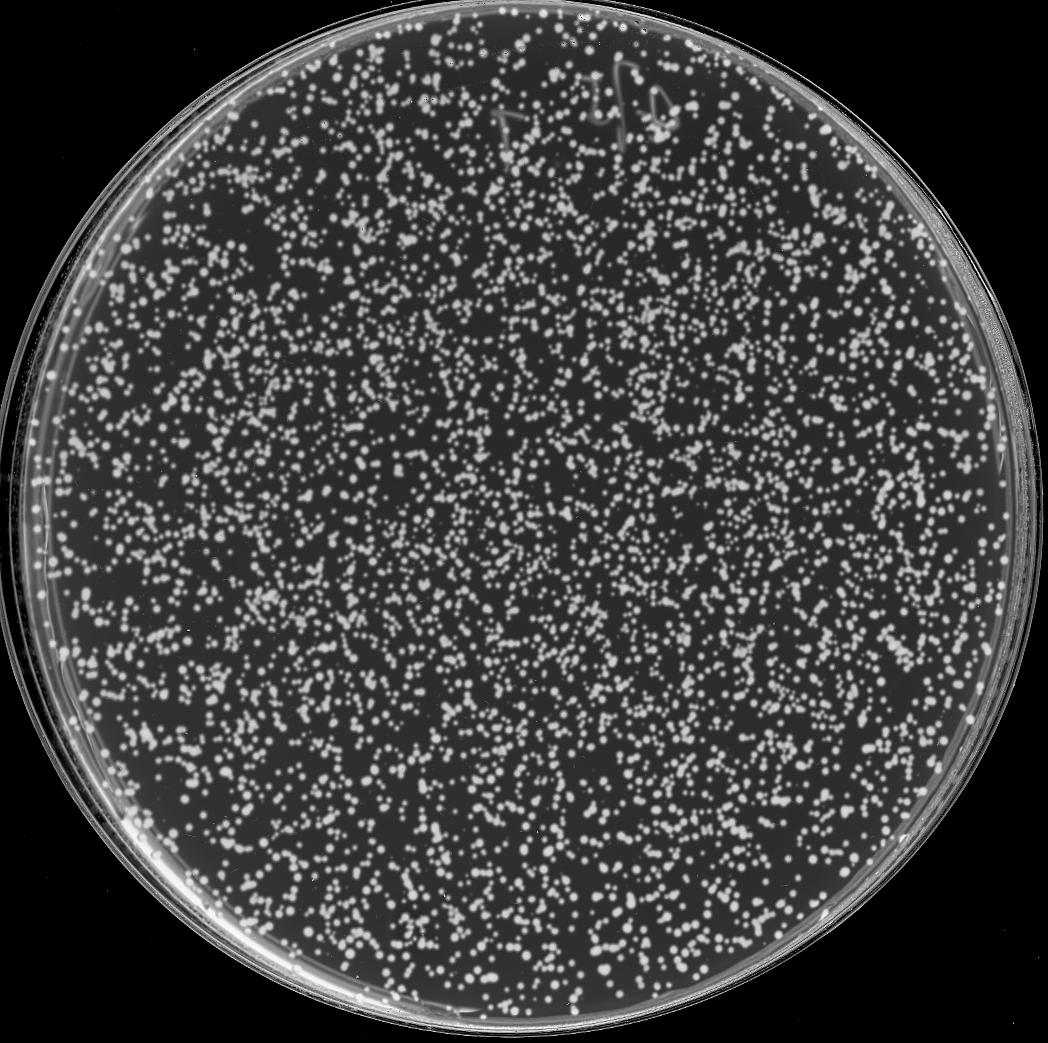
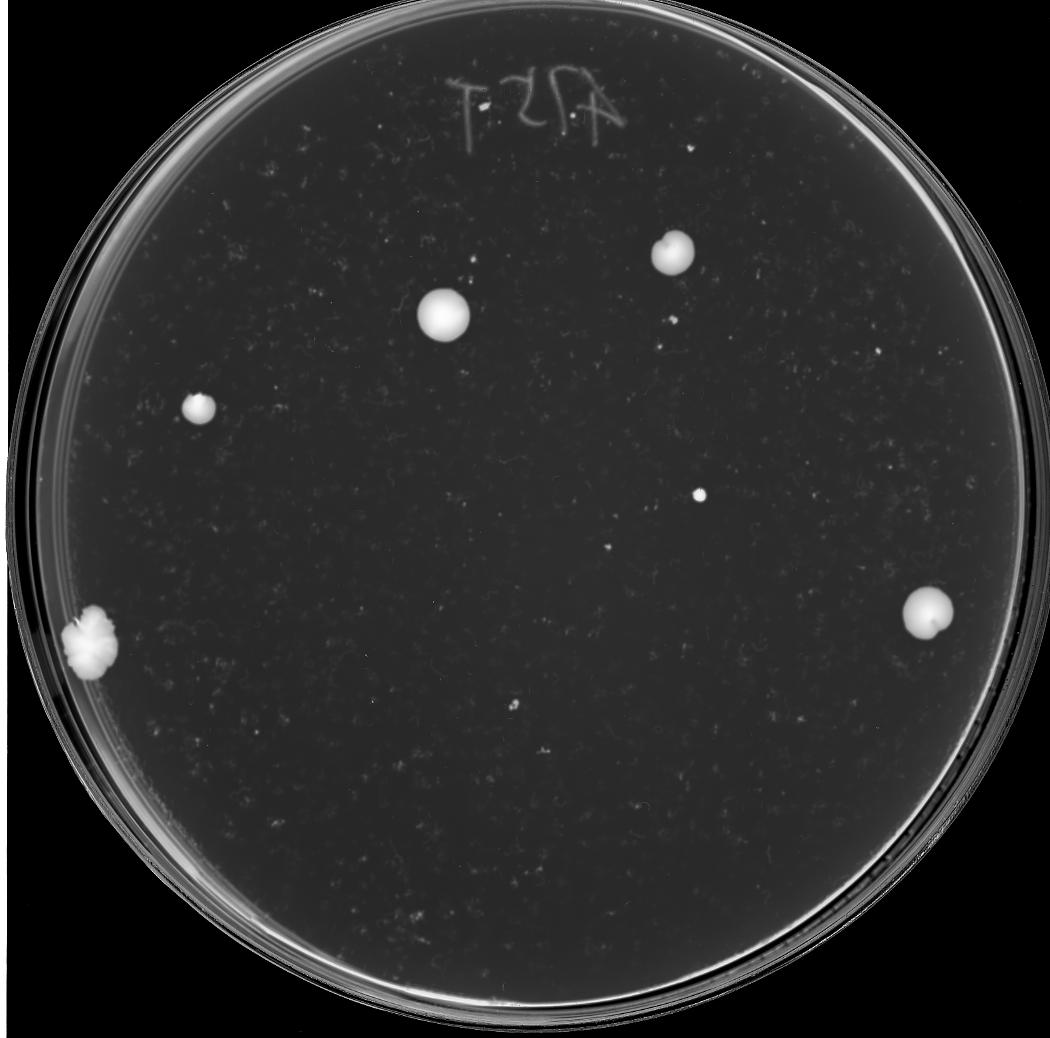
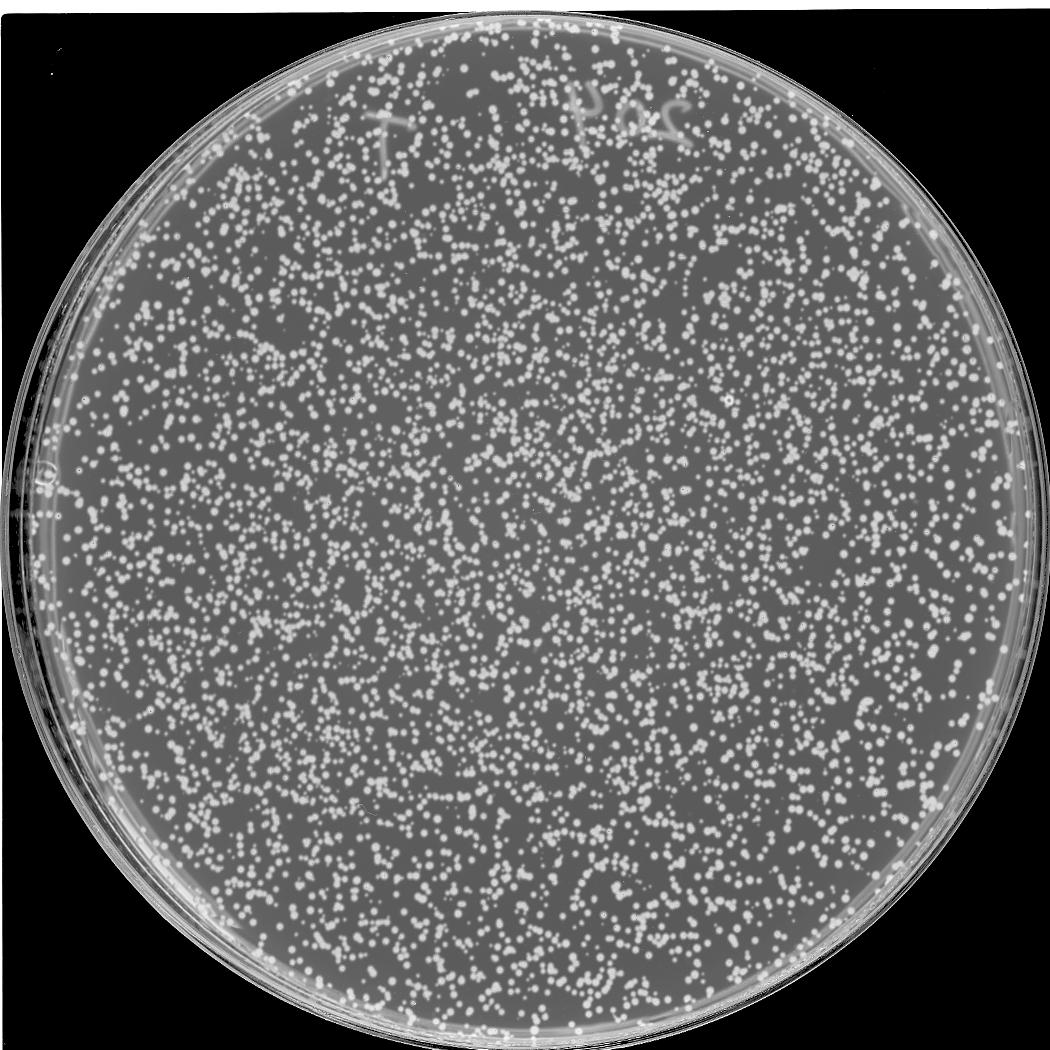

A
B
C
D
E

F
G

H

I

J
K

L

A: Candidate | Selection for the OE plasmid (suppressor overexpression ON)
B: Candidate | Selection for essential gene deletion and the OE plasmid, and counter-selection against the rescuing plasmid (suppressor overexpression ON)_4days
C: Candidate | Selection for essential gene deletion and the OE plasmid, and counter-selection against the rescuing plasmid (suppressor overexpression ON)_10days
D: Candidate | Selection for the OE plasmid (suppressor overexpression OFF)
E: Candidate | Selection for essential gene deletion and the OE plasmid, and counter-selection against the rescuing plasmid (suppressor overexpression OFF)_4days
F: Candidate | Selection for essential gene deletion and the OE plasmid, and counter-selection against the rescuing plasmid (suppressor overexpression OFF)_10days
G: Control | Selection for the OE plasmid (suppressor overexpression ON)
H: Control | Selection for essential gene deletion and the OE plasmid, and counter-selection against the rescuing plasmid (suppressor overexpression ON)_4days
I: Control | Selection for essential gene deletion and the OE plasmid, and counter-selection against the rescuing plasmid (suppressor overexpression ON)_10days
J: Control | Selection for the OE plasmid (suppressor overexpression OFF)
K: Control | Selection for essential gene deletion and the OE plasmid, and counter-selection against the rescuing plasmid (suppressor overexpression OFF)_4days
L: Control | Selection for essential gene deletion and the OE plasmid, and counter-selection against the rescuing plasmid (suppressor overexpression OFF)_10days